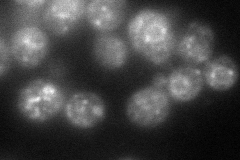
YPR075C
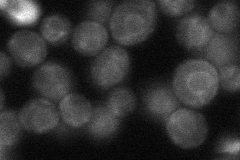
YPR075C
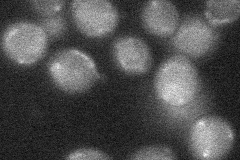
YPR075C
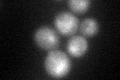
YPR075C

View description
Integral membrane protein that functions in the signaling branch of the high-osmolarity glycerol (HOG) pathway; interacts with Ste50p; overproduction blocks cell cycle arrest in the presence of mating pheromone
Localization:
Intensity:
Fold change:
Significance:
-
C’ GFP library in SD

cytosol24.36 -
N' NOP1pr-GFP in SD
ER,punctate95.7855 -
N' TEF2pr-mCherry in SD

punctate,vacuole61.6649 -
N' NATIVEpr-GFP in SD
ER36.4945 -
N' TEF2pr-VC and Cyto-VN in SD
below threshold24.4624 -
C’ GFP library in SD+DTT
cytosol30.611.25No -
C’ GFP library in SD+H2O2

cytosol25.571.04No -
C’ GFP library in Starvation Media

cytosol36.361.49No -
C’ GFP library on the background of Pup2-DaMP

N/A -
C’ GFP library on the background of CCT mutant

N/A0N/AYes
